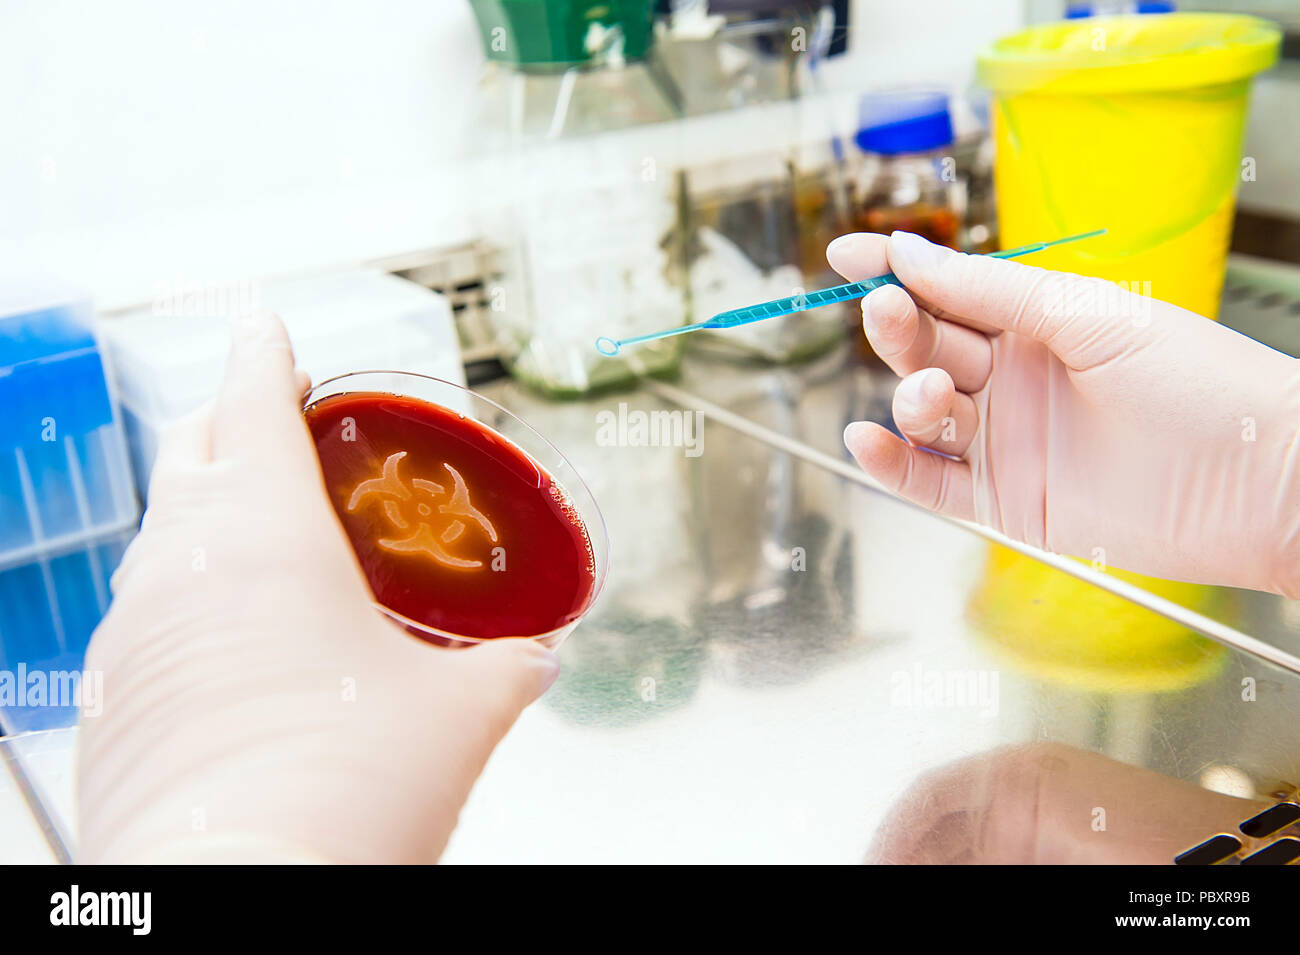

10 Agarplatten Petrischalen - Vorgegossen Für Wissenschaft & Schule
Express-Zustellung mit DHL GoGreen , wenn Sie innerhalb der nächsten 24 Stunden
- 1-2 Werktage Lieferzeit
- Kostenloser Versand ab 34 €
- 30 Tage kostenloser Rückversand
Produktdetails
Ready für spannende Experimente! Diese 10 vorgegossenen Agarplaten sind perfekt für den Bio-Unterricht, Wissenschaftsprojekte oder Hobby-Forscher. Einfach öffnen und loslegen - kein lästiges Schmelzen und Gießen mehr! Jede Petrischale ist bereits mit Nährboden gefüllt und versiegelt, damit nichts austrocknet. Ideal für Bakterienkulturen, Pilzzüchtung oder andere mikrobiologische Versuche. Die 7x7cm Größe ist praktisch und die gleichmäßige Dicke sorgt für zuverlässige Ergebnisse. Perfekt für STEM-Aktivitäten und junge Wissenschaftler! Größe: 7x7x1cm • Menge: 10 Stück • Material: Agar • Zustand: Vorgegossen, versiegelt • Anwendung: Mikrobiologie, Schulprojekte, Forschung • Besonderheit: Kein Vorbereiten nötig • Für: Schule, Labor, Hobby
Produktmeinungen (528)
Hinweis zur Verifizierung
Eine Prüfung, ob diese Produktmeinungen von Verbrauchern stammen, die die bewertete Ware tatsächlich genutzt oder erworben haben, hat nicht stattgefunden, es sei denn die jeweilige Bewertung ist als „verifizierte Meinung” gekennzeichnet.
Mehr Informationen zum Verifizierungsprozess
Durchschnitt aus 528 Meinungen
Die Durchschnittsbewertung berechnet sich aus 412 Cimenio und 116 externen Meinungen.
Cimenio vergütet seine BewertendenWeitere Informationen
Qualität und Nachhaltigkeit
- Klimaneutrales Unternehmen
- Geprüftes Vergleichsportal